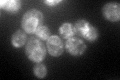
YGR284C
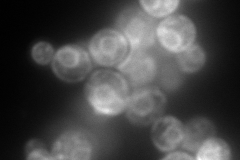
YGR284C
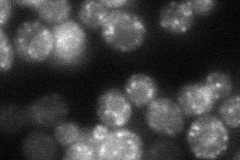
YGR284C
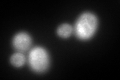
YGR284C
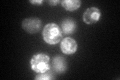
YGR284C

View description
Protein localized to COPII-coated vesicles, involved in vesicle formation and incorporation of specific secretory cargo
Localization:
Intensity:
Fold change:
Significance:
-
C’ GFP library in SD
punctate:ER69.62 -
N' NOP1pr-GFP in SD

ER,punctate205.363 -
N' TEF2pr-mCherry in SD
ER,punctate290.857 -
N' NATIVEpr-GFP in SD
punctate40.8995 -
N' TEF2pr-VC and Cyto-VN in SD

ER63.1061 -
C’ GFP library in SD+DTT
punctate.ER178.562.56Yes -
C’ GFP library in SD+H2O2

punctate.ER75.581.08Yes -
C’ GFP library in Starvation Media
punctate,ER146.22.09Yes -
C’ GFP library on the background of Pup2-DaMP

punctate:ER -
C’ GFP library on the background of CCT mutant

punctate:ER60.7890.873098No
